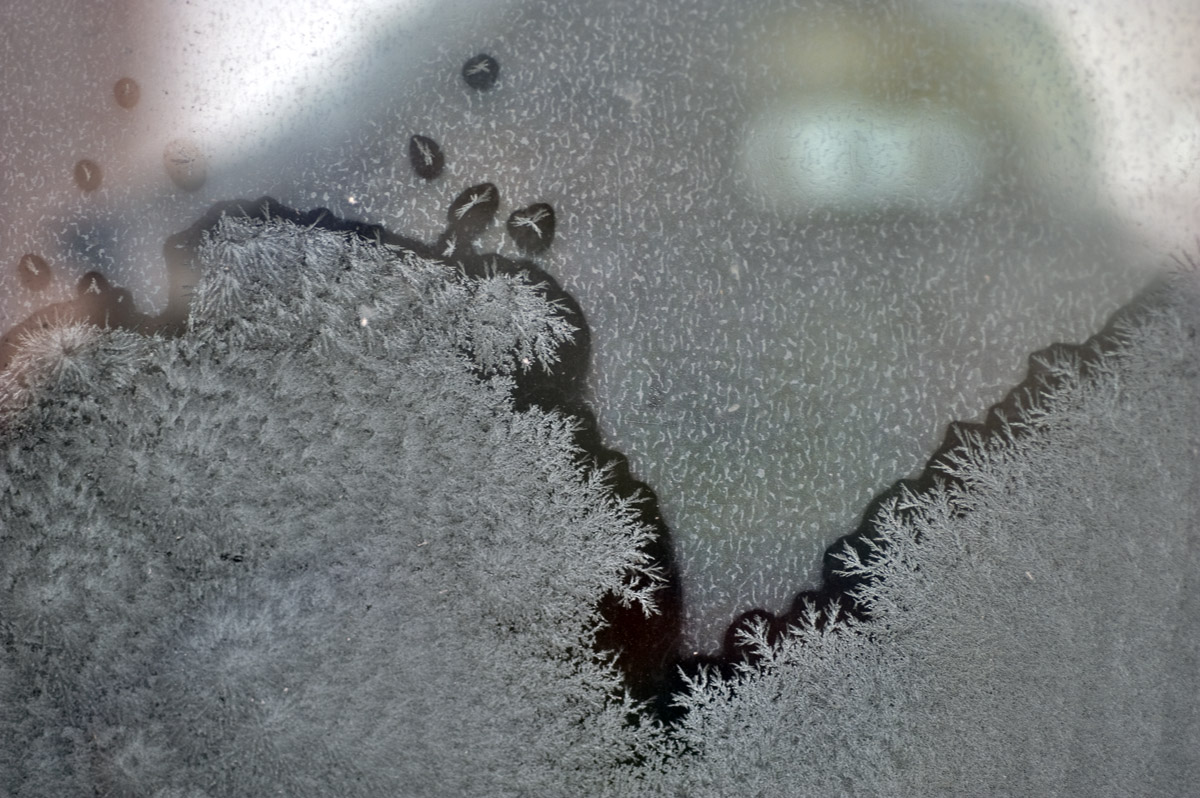

기기제조원: NIKON CORPORATION카메라모델: NIKON D700플래시: Flash did not fire초점거리: 60.0 mm조리개변경: 56/10노출방식: Aperture priority노출모드: Auto exposure노출시간: 1/400 sec노출보정: 1/-3W/B: Auto white balanceISO: 640촬영일자: 2012:01:06 08:16:29
기기제조원: NIKON CORPORATION카메라모델: NIKON D700플래시: Flash did not fire초점거리: 60.0 mm조리개변경: 32/10노출방식: Aperture priority노출모드: Auto exposure노출시간: 0.04 sec노출보정: 1/-3W/B: Auto white balanceISO: 200촬영일자: 2012:01:06 07:58:36

기기제조원: NIKON CORPORATION카메라모델: NIKON D700플래시: Flash did not fire초점거리: 48.0 mm조리개변경: 56/10노출방식: Aperture priority노출모드: Auto exposure노출시간: 1/125 sec노출보정: 2/3W/B: Auto white balanceISO: 200촬영일자: 2012:01:06 10:25:27

기기제조원: NIKON CORPORATION카메라모델: NIKON D700플래시: Flash did not fire초점거리: 60.0 mm조리개변경: 56/10노출방식: Aperture priority노출모드: Auto exposure노출시간: 1/125 sec노출보정: 1/-3W/B: Auto white balanceISO: 640촬영일자: 2012:01:06 08:27:28

기기제조원: NIKON CORPORATION카메라모델: NIKON D700플래시: Flash did not fire초점거리: 60.0 mm조리개변경: 56/10노출방식: Aperture priority노출모드: Auto exposure노출시간: 1/320 sec노출보정: 1/-3W/B: Auto white balanceISO: 640촬영일자: 2012:01:06 08:17:55

기기제조원: NIKON CORPORATION카메라모델: NIKON D700플래시: Flash did not fire초점거리: 60.0 mm조리개변경: 56/10노출방식: Aperture priority노출모드: Auto exposure노출시간: 1/80 sec노출보정: 1/-3W/B: Auto white balanceISO: 640촬영일자: 2012:01:06 08:14:36
겨울이 만들어낸 계절의 흔적입니다 .































.jpg)














.jpg)






























